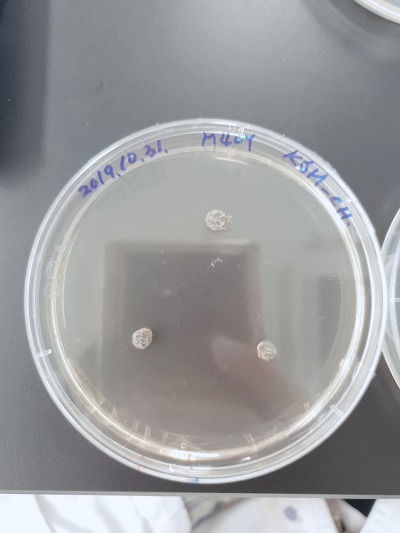
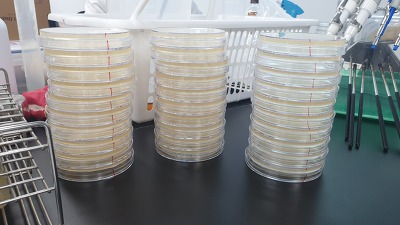

안녕하세요. 한국식품정보원 교육운영팀 입니다.
지난 2019년 10월 30일 ~ 11월 1일에는 대전교육장에서 곰팡이 실습 교육이 있었습니다.
정확한 교육과정명은 '식품 및 환경오염 곰팡이(진균)의 분리 동정 및 제어법(실습)' 입니다.
1년에 두 번 밖에 개설되지 않는 아주 ★유니크★한 교육이라 많이들 궁금하실텐데요
이 글에서 자세한 커리큘럼과 실제 교육을 들은 교육생의 후기를 안내해드릴게요.
(내용이 깁니다. 모바일보다는 컴퓨터 보시는 것을 추천합니다.^^)
★2020년 대전교육장 일정 (2일과정은 별도 문의)
1차 : 2020년 3월 18~20일
2차 : 2020년 10월 21~23일
★2020년 서울교육장 일정
1차 : 2020년 6월 24~26일 요약글 내용을 입력해 주세요.

★교육목표
국내 유일 곰팡이 동정 및 곰팡이 억제 시험 실습교육으로 각종 제품으로부터 오염진균을 분리하고, 분리한 진균의 형태학적 동정을 위한 육안 및 현미경을 통한 형태관찰의 기본 기술을 습득할 수 있으며, 각종 항진균 시험 이론 및 실습교육을 통하여 시험법을 익힐 수 있습니다.
★1일차
진균 기초지식 / 진균실험실의 기본설비와 안전수칙 / 무균조작법 / 진균용 배지 종류와 제작법 / 검체 취급 및 관찰법 / 검체의 접종과 배양
★2일차
식품별 주요 오염 곰팡이 / 진균의 형태학적 및 유전학적 동정법 / 적합균류 / 자낭균류 / 무성진균 / 포자액 제작법
★3일차
제조환경 검사법 / 진균발생사례 소개 및 대책토론
아래 사진은 무료로 나눠드리는 강의 교재입니다.
강사님께서 실제 쓰신 '진균검사매뉴얼' 교재로 강의가 진행됩니다.
다양한 곰팡이들이 보이시나요?
※ 참고로 이 교육과정을 강의해주시는 박사님은
일본위생미생물 연구소 소장님으로 일본 미생물 연구 분야의 권위자이며,
곰팡이 도감/ 진균검사매뉴얼의 대표저자 입니다.
아무래도 곰팡이는 식품 외에도 어디에서나 쉽게 발견이 되기때문에
식품제조회사뿐만아니라 다른 기관에서도 많이들 수강하러 오신답니다.
실제 실험기기제조업체, 살균제 및 시약 제조업체, 정수기 및 비데 등 렌탈업체, 반도체 제조업체, 주방용 전기기기 제조업체 등에서 오셨습니다.
(본 교재는 교육을 듣지 않으신분들에게도 판매하고 있으니 구매하고자하시면 전화주세요^^)

아래 사진들은 정보원에서 미리 준비한 곰팡이입니다.
곰팡이 종류가 정말 다양하죠?
교육생분들께서 원하는 곰팡이를 직접 현미경으로 관찰해보는 시간도 가졌습니다.










여기서부터는 실제 교육을 수강했던 교육생의 후기 입니다.
정말 자세하게 적어주셔서 너무나 감사했던 후기 입니다.
곰팡이 관련 교육을 찾고 계신 모든 재직자, 전공학생분들께 적극! 추천 드립니다.
http://cafe.daum.net/foodi114/QNY8/1332
다음카페 '식품안전의 모든것!' 교육후기 게시판에서 발췌하였습니다.

*교육날짜 : 2019.10.30~11.01(3일간)
*교육장소 : 한국식품정보원 대전분원 8층 미생물 실습실
*교육명 : 식품 및 환경오염 곰팡이(진균)의 분리 동정 및 제어법(실습)
*성함 : 김세호
(성함을 남겨주셔야 원활한 상품제공이 가능합니다^^)
-----------------------------
후기작성 양식
① 해당 교육을 신청하신 계기와 목적은 무엇인가요?
유가공업(치즈, 발효유)와 뗄레야 뗄 수 없는 그런 제품들이다 보니 자연스레 곰팡이에 대한 궁금함이 늘 있었습니다. 무엇보다 치즈에 유익한 곰팡이 페니실리움, 지오트리쿰 등에 대한 관심이 높아졌습니다. 숙성치즈에 관심도가 높아진 관리자들과 품질관리 제품개발 팀의 관심도 증가 등등, 도움이 될 것 같았고,
그리고 무엇보다 제품 클레임 역시 곰팡이가 주를 이루고 있어 현장에서 제어할 수 있을까하여 해당 교육을 신청했습니다.
② 해당 교육에 대한 전반적인 느낌은 어떠한가요? (교육 측면 / 시설 및 위치 측면)
- 교육 측면
오전에는 이론에 대한 부분을 강의해주셨습니다.
그동안 곰팡이에 대한 오해들이 해소되는 부분이 있었고요.
실제로 곰팡이에 대한 특징들과 해박한 박사님의 지식이 그대로 전수되는 기분이랄까요?
상당히 새로운 공부였음에 틀림없습니다.
박사님께서 곰팡이 포자액을 만드는 방법을 알려주시던 모습입니다.
이제는 저도 곰팡이 포자액을 만들 수 있게 되었습니다 ㅋㅋㅋㅋ
이론은 PPT는 몰론 판서를 하시면서 상세히 알려주셨습니다.
그 뿐 아니라 실 상황에서, 현장에서 궁금해하는 부분에 대해서도 상세히 알려주셨습니다.
실체현미경과 현미경을 직접 다루시면서 좀 더 잘 관찰할 수 있도록 도와주셨습니다.
현미경에 대해 조금 더 깊은 지식을 얻은 듯 ㅋ
함께 공부했던 분들의 초상권을 생각해서 그냥 모자이크 처리 ㅋ
박사님께서 실제 표본을 만드는 방법과 노하우를 전수해주셨던 장면입니다.
이것은 호건성 곰팡이로 추정되는 곰팡이를 기를 수 있는 배지~
배지명은 음.... 알려드리지 않을께요. 왜냐하면 가서 직접 배우는 게.... ㅋㅋㅋ
이것은 곰팡이를 보관하기 위해 만든 사면배지입니다.
사면배지에 있는 곰팡이에서 포자를 추출하여 포자액을 만들죠
사면배지로부터 얻어낸 곰팡이 포자액입니다.
그리고 오른쪽은 희석배수에 따른 희석액이고요.
이것은 곰팡이를 표본으로 만들어 현미경 관찰한 사진입니다.
이것은 락토페놀코튼블루 시약으로 포자낭을 염색하여 관찰한 사진입니다
이것은 제가 눈여겨 본 곰팡이로... 바로 페니실리움이죠...
요즘 제가 까망베르, 브리에 딱 관심을 갖고 있거든요.
요고 요고~ 암큼한 녀석들~ 쪼꼼만 기다려라~~~~
암튼, 3일 교육 너무 짧게 느껴질 정도로 흥미진진한 교육시간이었습니다.
기회가 된다면 더 더 더 더 더~~~ 많이 배우고 싶습니다.
- 시설 및 위치 측면
아쉽게도 실험실을 찍지는 못했지만 바로 실습이 가능하도록 미리 자리배치를 해주셨고,
실험이 쉽도록 해놓은 부분은 정말이지 이상적이었습니다.
다만, 실체현미경 가격이 얼마 안된다고 하셨는데... 한대뿐이여서 하나 더 있어도 되지 않았을까 싶습니다.
현미경 대수에 비해 적은 게 아닌가 싶어서... 한꺼번에 관찰하기가 좀 애매했습니다.
교육 장소와 집과의 거리가 사실 멀지 않아서 아침 저녁으로 왔다갔다 했는데요. 우선 자가용으로도 부담이 되지 않았습니다.
주차장이 교육장소와 불과 10미터 정도 밖에 떨어져있지 않아서 쉽게 오갈 수 있었고요.
만약에 어딘가 숙소를 정했다고 하더라도 지하철 역과 거리가 가까워서 유성쪽에서 머물렀으면 한두 정거장 정도 거리라 정말 편하게 오갈 수 있었을 거 같아요.
그리고, IC와 인접해서 출퇴근이 정말 용이했습니다.
가까운 인근에서 출퇴근 할 경우에도 이정도면 땡큐죠~ 최고의 입지, 장소였습니다.
③ 가장 도움이 됐거나 인상 깊었던 점은 무엇인가요?(강사 전문성/업무 적용성/네트워크 형성 등)
이 사진은 배지구분 방법입니다.... 아 이런 방법이....
우리나라보다는 선진화 되어 있는 새로운 방법들을 많이 배웠습니다.
그래서 현재 우리 회사에서도 사용합니다 ㅋㅋㅋㅋ
이렇게 쉽고 빠르게 구분할 수 있는 방법이 생겨서 매우 매우 기쁩니다.
그리고 박사님을 어디선가 뵌 것 같았습니다...
너무 낮이 익어서요...
그래서 혹시나 하고 회사에 돌아와 몇 해 전에 구매한 곰팡이도감을 펼쳐봤죠~
막연하게 곰팡이에 대해 공부해보려고... 반 강제로 구매했던 그 책~!!!!
두둥~!!!
교수님이 대표저자....
그리고 그 곰팡이 도감...
나눠주신 진균검사 매뉴얼이 더 상세히 적혀 있는 곰팡이 도감.....
우와... 그래서 이 도감과 함께 곰팡이에 대해 더 공부하고 있습니다.
곰팡이의 특성과 발생 원리에 대해 배우고 나니 현장에서 발생하는 곰팡이에 대해 더 잘 알게 되었습니다.
적을 알고 나를 알면 백전백승이라고 했던가요?
이렇게 적을 조금 더 알게 되니, 자신감도 생깁니다.
아직 갈 길이 멀지만, 열심히 곰팡이에 대해 알아가겠습니다.
④ 해당 교육을 추천한다면, 그 대상과 이유는 무엇인가요?
미생물을 공부했고, 곰팡이에 대해 더 궁금하거나, 유가공업에 종사하는 분들, 그리고 식품에서 종사하시는 품질관리 분들이 알면,
더 좋은 환경에서 안전한 먹거리를 생산할 수 있을 것 같습니다.
사실, 모든 식품에서 제일 많이, 그리고 흔하게 볼 수 있는 곰팡이 클레임.
그 대책의 시작이 곰팡이에 대해 잘 아는 것이 아닐까요?
⑤ 향후 정보원의 타 교육과정에 대한 수강계획 혹은 개설되었으면 하는 과정이 있으신가요?
당연히 많겠지만, 우선은 곰팡이에 대한 심화과정이 있었으면 하죠~
이번에 배우지 못한 부분까지 더 자세히 배우는 시간이 있었으면 더더더 좋겠습니다.
그리고 끝으로 인사 한마디
교육의 편의를 제공해주신 한국심품정보원 교육 운영진 조교님(이름이 생각이 안나네요.)과 애써주신 박사님~~!!!!
진심으로 감사드립니다.
다음에 또 뵐 기회가 있었으면 좋겠습니다.